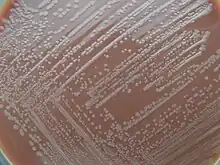

Gélose chocolat
Trois types de géloses "Chocolat" comme milieu de culture coexistent :
- La gélose chocolat
- La gélose chocolat supplémentée
- La gélose au sang cuit
Ces trois géloses présentent la caractéristique commune d'être de couleur chocolat sans contenir de traces de chocolat.
Usage
Ces géloses ont été inventées pour permettre la culture et l'isolement de microorganismes exigeants qui ne cultivent pas ou mal sur gélose au sang frais, en particulier les Neisseria et les Hæmophilus. Les microorganismes non exigeants cultivent sur ces différents milieux.
Composition
La gélose au sang cuit
La gélose au sang cuit est le premier milieu apparu pour la culture des microorganismes exigeants. À la base riche (milieu Columbia par exemple) est ajouté du sang frais (cheval-mouton) puis le milieu est chauffé avec agitation dans un bain d''eau vers 80 °C jusqu'à l'obtention d'une couleur chocolat. Il peut alors être coulé en boite. Ce milieu équivaut à la gélose Chocolat supplémentée.
La gélose chocolat
La gélose Chocolat est obtenue d'une façon comparable avec chauffage en ajoutant à la base non du sang mais une solution d'hémoglobine. Ce milieu est commercialisé en flacon prêt à l'emploi. La composition de l'ensemble est la suivante :
- Peptone trypsique de caséine 7,5 g
- Peptone pepsique de viande 7,5 g
- Amidon de maïs 1,0 g
- Hydrogénophosphate de potassium 4,0 g
- Dihydrogénophosphate de potassium 1,0 g
- Chlorure de sodium 5,0 g
- Hémoglobine 10,0 g
- Agar 15,0 g
- PH = 7,2
La gélose chocolat supplémentée
Le supplément de la gélose, commercialisé par exemple sous le nom de Polyvitex, est ajouté à la gélose Chocolat en surfusion à 50 °C:
- Supplément glucosé, vitaminé type Polyvitex 1,0 mL pour 100 mL de milieu
Il est composé de glucose, de nitrate de fer III, de L-glutamine, de L-cystine et L-cystéine, d'adénine, de guanine, d'acide 4-aminobenzoïque, de NAD+, de thiamine pyrophosphate et de cobalamine. Il apporte donc de nombreux coenzymes ou précurseurs, des bases azotées, des acides aminés, du fer III, et du glucose.
Différences de composition des géloses
Le sang contient des inhibiteurs de culture de certaines bactéries. Ces inhibiteurs sont détruits par la chaleur. Il s'agit probablement entre autres de libérer les ions du fer des transporteurs plasmatiques.
L'hémoglobine apporte un coenzyme ou un précurseur de coenzyme, l'hémine.
Les milieux de base ne contiennent pas de NAD/NADH : le sang cuit l'apporte mais pas l'hémoglobine. Le supplément ajouté complète la gélose Chocolat en apportant ce coenzyme.
La gélose au sang cuit est équivalente à la gélose Chocolat supplémentée (ou enrichie) mais sa composition est inconstante et peu reproductible. Les normes de qualité et la standardisation conduisent à l'adoption de milieux prêts à l'emploi.
Utilisation
La gélose Chocolat supplémentée est utilisée pour isoler des microorganismes exigeants : elle est le milieu polyvalent pour la plupart des pathogènes cultivant en aérobiose. Elle est indispensable pour les Neisseria pathogènes et les Hæmophilus.
En effet, Hæmophilus contient deux espèces exigeantes :
- H. influenzae qui exige absolument NAD et hémine : il ne cultive que sur gélose Chocolat supplémentée
- H. parainfluenzae qui exige absolument l'hémine : il cultive sur gélose Chocolat et Chocolat supplémentée
Ces géloses peuvent donc être utilisées pour différencier ces deux genres.
Milieux sélectifs basés sur la gélose Chocolat supplémentée
L'addition d'inhibiteurs permet un isolement sélectif, particulièrement utile quand une flore associée est importante comme dan le prélèvement vaginal ou le prélèvement bronchique.
Cas des Neisseria
Le milieu utilisé, nommé Thayer et Martin, est une gélose Chocolat supplémentée additionnée de, pour 1 L de milieu :
- Vancomycine : 3,0 mg
- Colimycine : 7,5 mg
- Fungizone = Amphotéricine B : 2,0 mg
- et parfois de Trimetroprime
L'addition des inhibiteurs est réalisée avec celle du supplément.
La vancomycine inhibe de nombreux Gram +, la Colimycine de nombreux Gram - et l'amphotéricine les champignons, en particulier les levures du genre Candida.
Il est utilisé en particulier pour le prélèvement vaginal et le prélèvement de gorge pour la recherche de Neisseria gonorrheae et N. meningitidis.
Cas des Haemophilus
L'inhibiteur utilisé est la bacitracine à 50 kUI par Litre de gélose Chocolat supplémentée.
Le milieu permet l'isolement sélectif des Haemophilus notamment dans le prélèvement bronchique ou les crachats.
Voir aussi
Sources
- Joffin Jean-Noël, Leyral Guy, Dictionnaire des Techniques, CRDP d'Aquitaine réseau Canopé, 2014, 5e édition, 418 p., (ISBN 978-2-8661-7515-3)